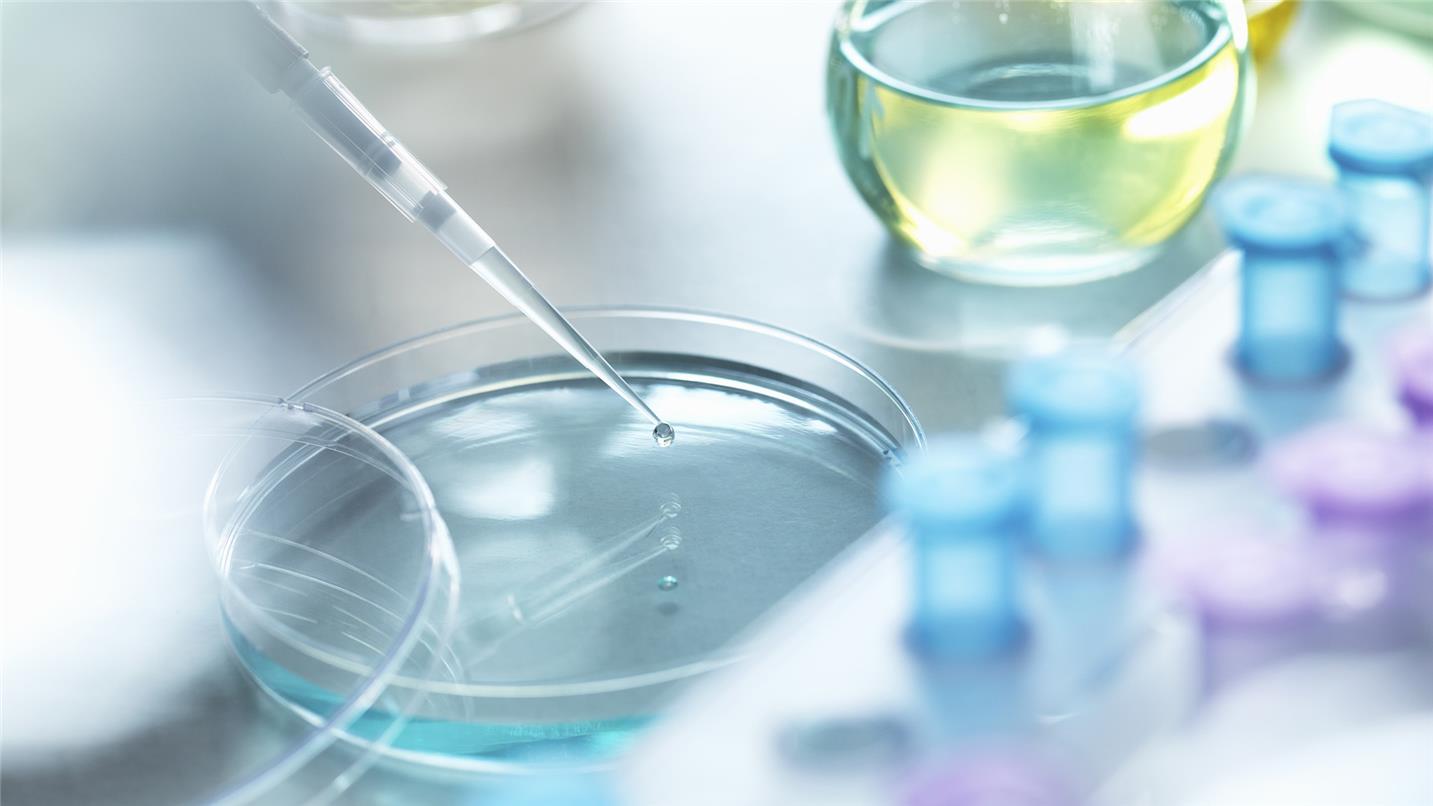
Healthcare

Your challenges
Similar challenges apply to industrial and domestic water systems, as well as their potentially confusing framework of legislation and best practice guidance. For many hospitals, improvements in the way their water systems are designed and managed can be a significant and under-exploited opportunity to achieve savings while also ensuring full compliance.
At the same time, healthcare managers need to show a commitment to sustainability and minimising waste in all areas.
Our solutions
SUEZ
helps NHS hospitals and other healthcare premises improve the
sustainability and efficiency of their industrial and domestic water
systems, and their waste management.
Our water solutions achieve environmental benefits while reducing the
operating costs of treatment plants for water and effluent. They
include:
- Advanced water purification systems for applications ranging from low-volume laboratory units to high-flow ring-main solutions for sterile services, decontamination and renal dialysis departments.
- Protection against waterborne, hospital-acquired infections using chemicals developed by our highly qualified chemists to eliminate pathogens such as Legionella.
- Greater energy efficiency and cost savings from our range of engineered chemicals and dosing systems for boiler, cooling and hot and cold-water systems.
- Training in best practice safety protocols and processes for water systems in healthcare environments.
Our waste management service is comprehensive too. We audit waste flows
and existing practices, and design a tailored solution – so it supports
the efficiency of your operations as well as safeguarding staff,
patients and public.
We will ensure the safe and compliant segregation, storage, carriage, treatment and disposal of all wastes, including:
- General waste and recyclables.
- Hygiene waste.
- Pharmaceutical waste.
- Hazardous waste
- Radioactive waste.
- Sharps.
Our expertise
With
more than 40 years’ experience managing water and waste, SUEZ in the UK
can also draw on a bank of world-leading expertise within our global
group.
We offer the widest range of water purification systems,
chemicals, training and support services available from a single source.
This enables us to guarantee exceptional levels of water quality,
safety and hygiene.
SUEZ also has the specialist expertise and
national network of facilities to put wastes to good use, as well as
assuring complete compliance.
Our waste expertise extends from
segregation and logistics to treatment and operation of facilities for
processing hazardous wastes, including high-temperature incineration.
Our
staff are highly experienced in catering for the demands of hospitals,
clinics, dentists, nursing homes, and all generators of healthcare waste
of whatever size.